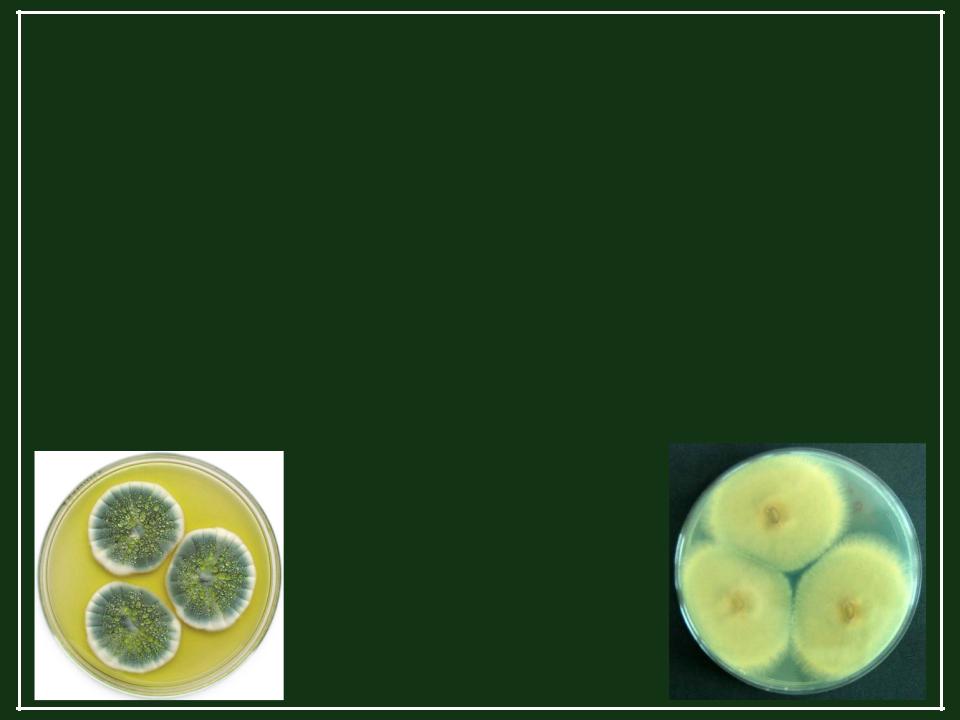

Материал: Лекарственные грибы

Антибиотики в медицине
Антибиотики – образуемые микроорганизмами вещества, способные подавлять рост других микроорганизмов (Ваксман, 1942). Сейчас это определение расширено и включает искусственно синтезированные соединения.
Антибиотики образуют в ходе вторичного метаболизма
бактерии, актиномицеты (Streptomyces) и грибы.
Медицинское значение антибиотиков очень велико, т.к. многие инфекционные болезни человека вызывают бактерии
(пневмония, ботулизм, холера, дизентерия, сибирская язва, столбняк, стафилококковый менингит и др.), и они же являются причиной многих внутрибольничных инфекций.
Антибиотики – один из столпов современной медицины (Ball et al., 2004).

Антибиотики в медицине
Аналогом антибиотических препаратов в Древнем мире были
«лечебные плесени», например, к ранам прикладывали куски заплесневелого хлеба. Это практиковалось в древней Греции, Египте (1500 л. до н.э.), упоминания имеются в Талмуде (чамка – заплесневелое зерно, вымоченное в финиковом вине). Китай, 3000 л. назад: для лечения ран применяли плесень с соевых бобов (Wainwright, 1989 a,b).
Англия, 1640 г.: аптекарь из Лондона, королевский врач Джон Паркингтон советовал применять плесени аналогичным образом.

Антибиотики в медицине
«Побывав в центральной Европе в 1908 г., я с удивлением обнаружил, что в деревнях в кухнях хранят плесневелый хлеб. Когда я спросил, зачем это делается, мне ответили, что это старый обычай, и если кто-то из членов семьи получит порез или ссадину, от хлеба отрезают тонкий ломтик, размачивают в воде и прикладывают полученную кашицу к ране. Я был поражен тем, что при таком лечении не возникает заражений» (А.Э.
Клиффе, канадский биохимик).
Таким же образом лечили раны домашних животных.
Импетиго – кожное заболевание, вызываемое стафилококком. Достоверно известны случаи излечения плесенью в Европе в начале XX в.
Антибиотики в медицине
Ирландия: давняя традиция лечения плесенью кожных заболеваний. Это лечение появилось задолго до того, как выяснилось, что причиной служит бактерия стафилококк.
Зачастую народная медицина оказывалась эффективнее, чем официальная, хотя многие ученые оспаривают этот факт. При всем разнообразии возможных схем лечения, во всех регионах использовали только плесень с разных сортов хлеба,
зерна, овощей, фруктов. Опасность лечения заключается в возможном токсинообразовании и попадании в организм
потенциальных возбудителей микозов.
Aspergillus fumigatus
Penicillium chrysogenum

Грибные антибиотики в медицине
Механизмы действия антибиотиков:
•нарушение синтеза клеточной стенки;
•нарушение функционирования мембран;
•подавление синтеза нуклеиновых кислот;
•нарушение синтеза белка;
•ингибирование работы дыхательных ферментов.
Для характеристики активности препарата используется понятие «единица биологической активности», обычно в единицах массы: мкг/мл.
Для ряда антибиотиков приняты условные единицы : ед./мл раствора или ед./мг препарата.